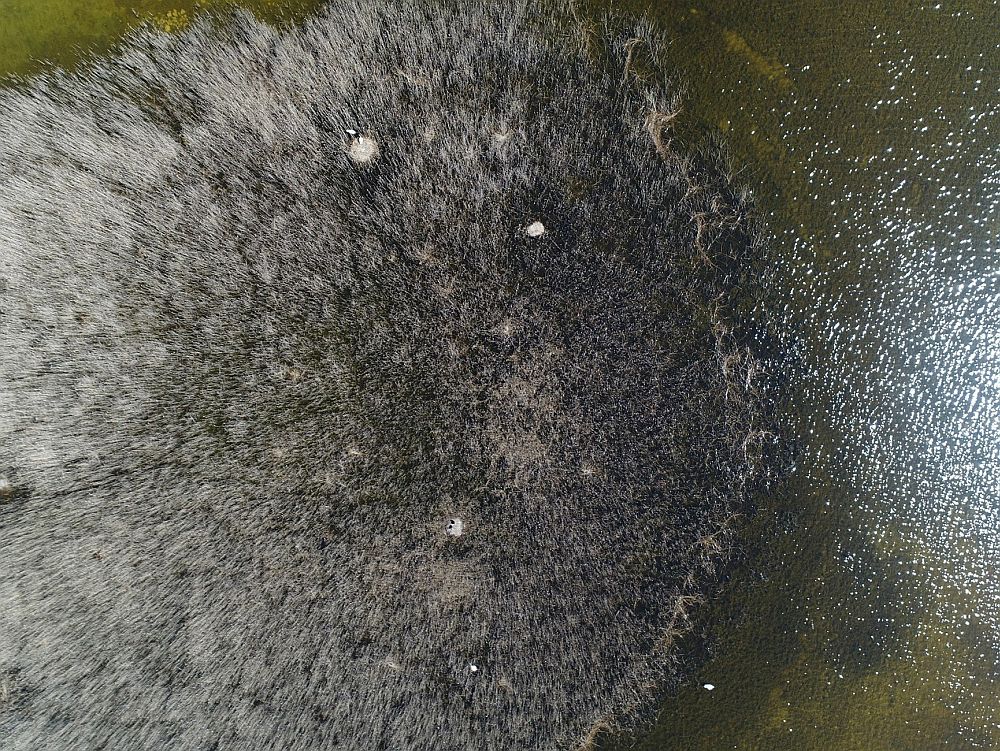

Linnuvaatleja teadusuudis, www.linnuvaatleja.ee
Kuigi droonide lennutamine on muuhulgas populaarne ajaviide, kasutatakse üha enam droone ka teadusliku, sealhulgas ornitoloogilise informatsiooni kogumiseks.
Võrreldes teiste uurimismeetoditega on droonide kasutamise eelisteks suhteline kulusäästlikus ning linde vaid vähesel määral häiriv hea resolutsiooniga ruumilise andmestiku kogumine. Kuna mitmete linnuliikide uurimise teeb raskeks pesitsemine raskesti ligipääsetavates kohtades, on drooni abil võimalik nii looduskaitselistel kui ka teaduslikel eesmärkidel uurida alasid, mida mõnel muul moel ei ole võimalik külastada. Näiteks väikesaartel või laidudel pesitsevad linnud muutuvad inimese lähenedes ärevaks või põgenevad, mis raskendab nende kohta informatsiooni kogumist.
Estany d’Ivarsi Vila-Sana märgala on Kataloonia oluline turismipiirkond ja linnukaitseala. Sealsel väikelaiul, millel pikkust 170 ja laiust 50 meetrit, pesitsevate naerukajakate (Larus (Chroicocephalus) ridibundus) arvukuse ajalise ning ruumilise muutlikkuse uurimiseks kasutati justnimelt droone, kuna paadiga linde häirimata ei olnud laiule võimalik saada lähemale kui 100 meetrit. Laiu külastamine raskendanuks aga pesade leidmist ja suurendanuks nende hukkumise tõenäosust kiskluse läbi.

Naerukajaka koloonia Tondisaarel Võrtsjärvel / foto: Arne Ader (www.loodusemees.ee)
Kord nädalas drooniga 30 – 40 meetri kõrgusel kiirusega 30 – 40 km/h lendamine ja laiul toimuva pildistamine pesitsusperioodil aga linde ei häirinud ning tavaliselt vaenlaste suhtes agressiivselt käituvad kajakad ei rünnanud drooni kordagi. Drooni lennutati sõltuvalt ilmast igal lennupäeval koloonia kohal 2 – 4 korda.
Salvestatud fotodelt mõõdeti pesade asukohad ning nende omavahelised kaugused, mille põhjal hinnati koloonia suurus. Selgus, et kui pesitsusperioodi alguses ehitasid linnud pesi naabrist 3 meetri kaugusele, siis pesitsevate paaride lisandudes kahanes see 1 – 1,5 meetrini, kasvades 2 meetrini pesitsushooaja lõpus.
Drooni abil kogutud pesitsusedukuse ning pesade asustatuse andmed näitasid, et edukad olid vaid 34% pesitsustest. Kokku eristati laiul kolme kolooniat, neist suurimas õnnestus pesitsus 53%-l, kahes väiksemas vaid 14%-l ja 6%-l paaridel. Edukamad olid paarid, kes alustasid pesitsusega varem, pesitsesid koloonia keskmes ja rajasid pesa naabri lähedusse. Uurimistöö autorid arvavad, et ilmselt on siin suur roll ameerika naaritsa ehk mingi poolt tingitud ohul – koloonia servaaladel ja teistest kaugemal pesitsevaid paare on kergem rünnata.
Tuleb märkida, et uuring tehti juba 2011. aastal, mil droonide kasutamine lindude uurimiseks oli suhteliselt uudne. Tänapäeval kasutatakse droone juba väga laialdaselt nii näiteks röövlindude ja künnivareste pesade uurimiseks kui ka roostikus pesitsevate suurte veelindude pesade loendamiseks.
Roostikust leiab suurte veelindude pesad drooni abil kerge vaevaga üles / foto: Aarne Tuule
Sardà-Palomera F, Bota G, Padilla N, Brotons L, Sardà F (2017). Unmanned aircraft systems to unravel spatial and temporal factors affecting dynamics of colony formation and nesting success in birds. Journal of Avian Biology. Accepted Author Manuscript doi:10.1111/jav.01535
Linnuvaatleja teadusuudiseid toimetab Tartu ülikooli linnuökoloogia teadur Marko Mägi, marko.magi/at/ut.ee



